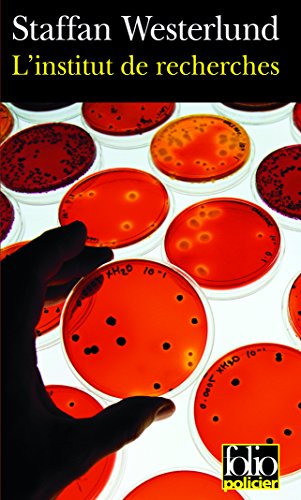
L' institut de recherches

Chargement...
| Auteur(s) : | Staffan Westerlund |
|---|---|
| Collection : | Folio |
| Editeur : | Gallimard (FR [Paris]) |
| Cette édition : | 2005 |
| Prix neuf : | 6.2 EUR |
| Code-barres : | 9782070314171 |
| Dimensions : | 18 cm |
| Volume : | 343 p. |
| Autre : | couv. ill. en coul. |
| Titre original : | Institutet |